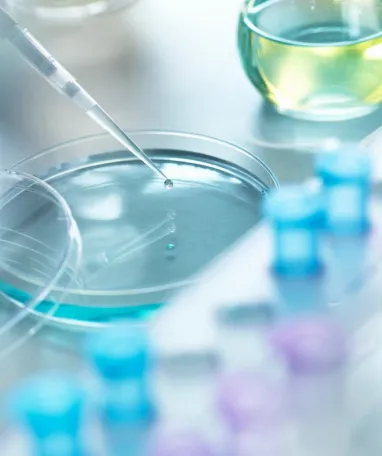

We’re looking for young talent to join our Challenging U Sales program.
At Challenging U Sales, we value a balance between technical and commercial skills, as we believe this combination is essential for success in our business areas.
Discover the kind of profile we're looking for to join our team:
- Recent graduates in Chemical Engineering, Industrial Engineering, Business Administration and Management, Chemical Sciences or Physics.
- High proficiency in English.
- Available for national and international travel and relocation, especially within Europe.
- Advanced knowledge of Microsoft Office, especially Excel.
- Exceptional interpersonal skills with a focus on customer satisfaction.
- Knowledge of French and Portuguese is a plus.
What will your Challenging U Sales experience be like?
You’ll engage in exclusive programs that will provide you with a diverse and enriching experience, offering the opportunity to rotate through different business areas such as Chemicals, Mobility & New Commerce, and Commercial & Clean Energies over three years.
Why join Moeve Challenging U Sales?
- You’ll develop commercial and customer service skills in a dynamic and innovative environment.
- You’ll discover the unlimited potential of the commercial sector: where every conversation is an opportunity, every negotiation is an exciting challenge, and every deal closed is a victory.
- You’ll transform your sales skills into a rewarding career full of possibilities.
- You’ll be a driving force in our growth and part of a team where your dedication translates into tangible success.
- You'll be part of a diverse and collaborative team, where both professional and personal growth are encouraged.
- We offer a permanent contract, a specialized master's degree in the commercial field from a prestigious business school, medical insurance, and a comprehensive package of social benefits.
Don't miss the chance to be part of our team and take your career to the next level with Moeve Challenging U Sales!
Apply now and get ready for an exciting professional journey.